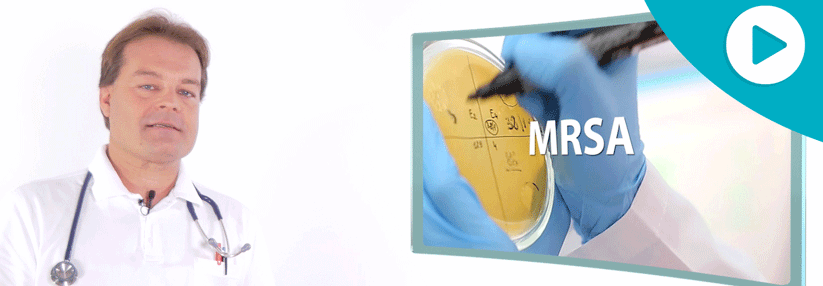

MRSA: Kaum Optionen gegen mehrfach resistente Gramnegative und Enterokokken
 Hartnäckig: Diese Bakterien sind unempfindlich gegen Cotrimoxazol, Ampicillin,
Enrofloxacin, Cefalexin und Clindamycin.
© wikimedia/Uwe Gille
Hartnäckig: Diese Bakterien sind unempfindlich gegen Cotrimoxazol, Ampicillin,
Enrofloxacin, Cefalexin und Clindamycin.
© wikimedia/Uwe Gille
In Krankenhäusern, die alle aufgenommenen Patienten screenen, liegt die Rate an MRSA-Trägern derzeit bei 1,5 %. Mit multiresistenten gramnegativen Bakterien (MRGN) sind dagegen 3,6 % besiedelt und mit Vancomycin-resistenten Enterokokken (VRE) 2,1 %. Gegen vier Antibiotikaklassen (inklusive Carbapeneme) resistente gramnegative Erreger (4MRGN) sind zwar noch selten. Aber auf Intensivstationen liegt der Anteil mancher dieser Spezies bereits im zweistelligen Prozentbereich, berichtete Professor Dr. Christoph Lübbert von der Infektions- und Tropenmedizin am Universitätsklinikum Leipzig. An Infektionen durch VRE erkranken vor allem gastroenterologische und hämatoonkologische Patienten.
Hoch…
Bitte geben Sie Ihren Benutzernamen und Ihr Passwort ein, um sich an der Website anzumelden.













